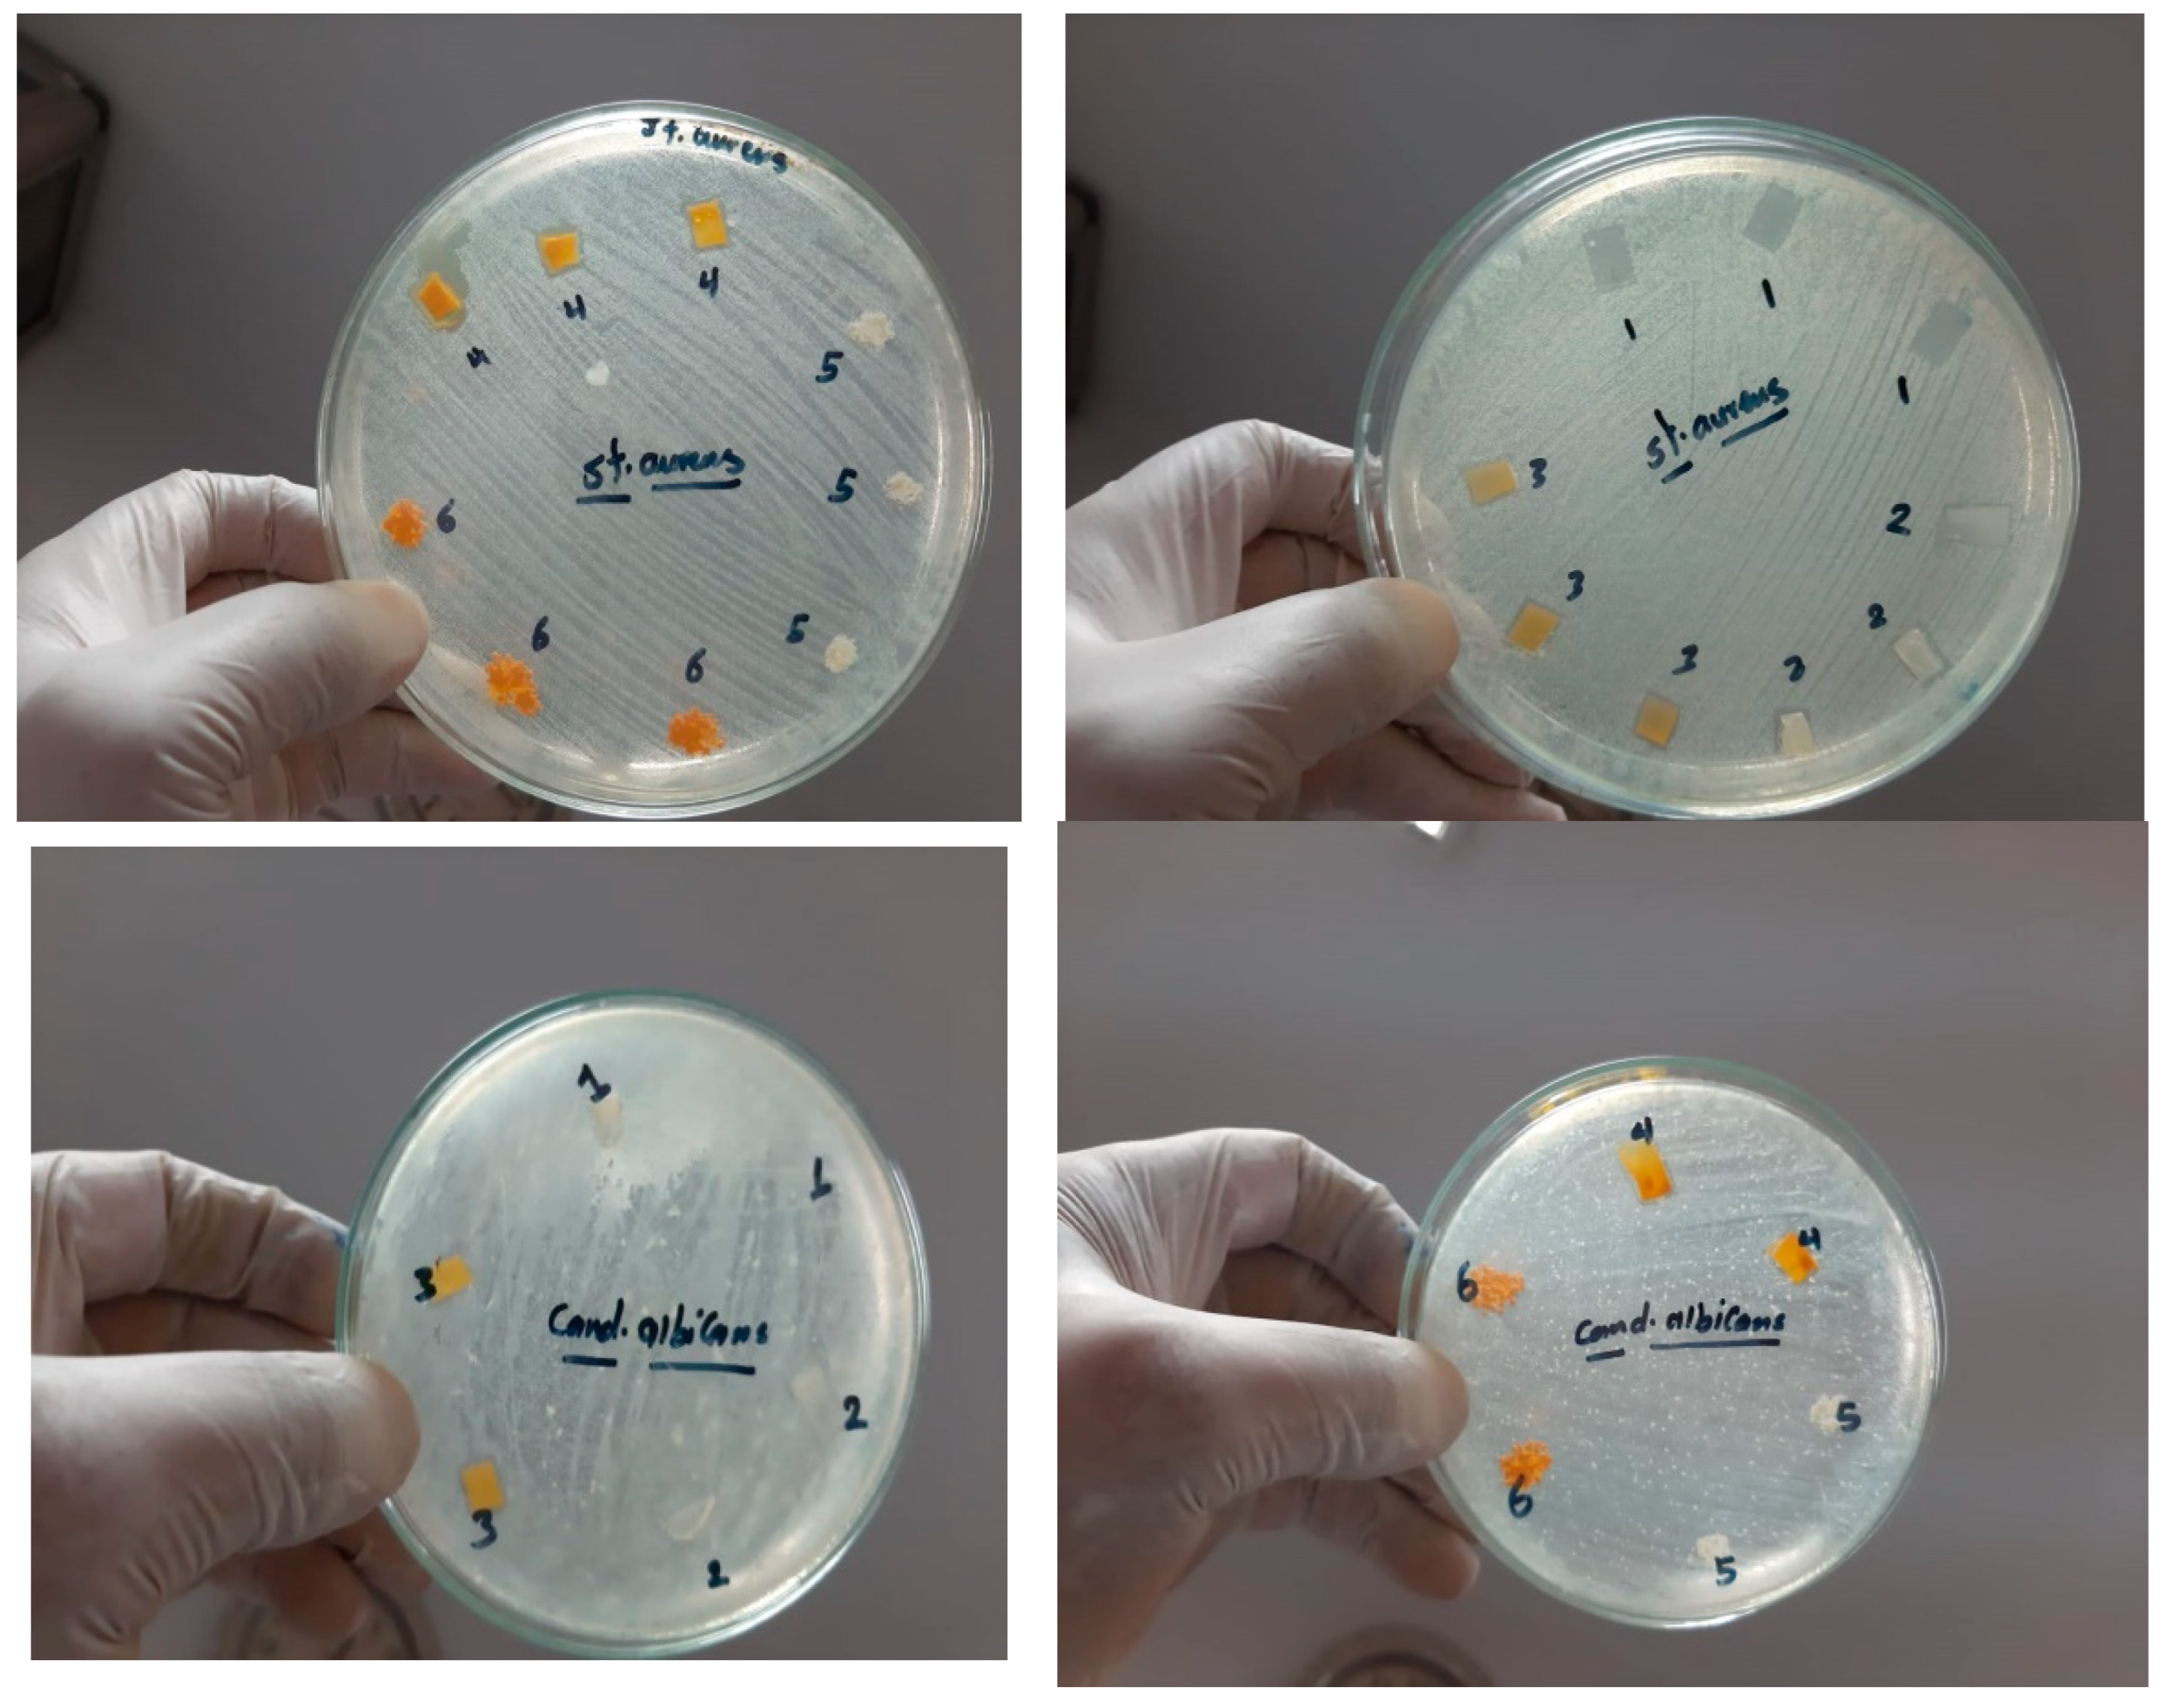
Nanomaterials 15 00082 g009b

Designing and Fabrication of Nano-Hydroxyapatite and Curcumin-Loaded Chitosan/PVA Nanofibrous Mats for Potential Use as Wound Dressing Biomaterials
Abstract
1. Introduction
2. Materials and Methods
2.1. Materials
2.2. Preparation of Nano-Hydroxyapatite
2.3. Preparation of Nanofiber Mat Blends
2.4. Characterization
2.5. Antimicrobial Activity
2.6. In Vitro Drug Release Studies
2.6.1. HPLC Method for the Quantitative Analysis of Curcumin
2.6.2. Mathematical Modeling of the Kinetics Release
2.7. Cell Cultures and Cells Viability
3. Results and Discussion
3.1. Characterization of Nano-Hydroxyapatite
3.1.1. XRD Analysis
3.1.2. HR-TEM
3.1.3. Fourier Transform Infrared Spectroscopy
3.2. Characterization of As-Spun Mats
3.2.1. Nanofiber Morphology and EDS Analysis
3.2.2. Composition of the As-Spun Mats
XRD Analysis
Fourier Transform Infrared Spectroscopy
3.3. Antimicrobial Activity
3.4. In Vitro Release Profile of CS/PVA/Cur and CS/PVA/HA/Cur Nanofiber Mats and Kinetic Study
3.5. Evaluation of Cell Viability
4. Conclusions
Author Contributions
Funding
Data Availability Statement
Conflicts of Interest
References
- Wang, J.; Cai, N.; Chan, V.; Zeng, H.; Shi, H.; Xue, Y.; Yu, F. Antimicrobial hydroxyapatite reinforced-polyelectrolyte complex nanofibers with long-term controlled release activity for potential wound dressing application. Coll. Surf. A Physicochem. Eng. Asp. 2021, 624, 126722. [Google Scholar] [CrossRef]
- Ranjbar-Mohammadi, M.; Rabbani, S.; Bahrami, S.H.; Joghataei, M.T.; Moayer, F. Antibacterial performance and in vivo diabetic wound healing of curcumin loaded gum tragacanth/poly(ε-caprolactone) electrospun nanofibers. Mater. Sci. Eng. C 2016, 69, 1183–1191. [Google Scholar] [CrossRef] [PubMed]
- Sedghi, R.; Shaabani, A.; Mohammadi, Z.; Samadi, Y.; Isaei, E. Biocompatible electrospinning chitosan nanofibers: A novel delivery system with superior local cancer therapy. Carbohydr. Polym. 2017, 159, 1–10. [Google Scholar] [CrossRef] [PubMed]
- Luo, X.; Lim, L. Curcumin-loaded electrospun nonwoven as a colorimetric indicator for volatile amines. LWT—Food Sci. Technol. 2020, 128, 109493. [Google Scholar] [CrossRef]
- Mutlu, G.; Calamak, S.; Ulubayram, K.; Guven, E. Curcumin-loaded electrospun PHBV nanofibers as potential wound dressing Material. J. Drug Deliv. Sci. Technol. 2018, 43, 185–193. [Google Scholar] [CrossRef]
- Maheshwari, R.K.; Singh, A.K.; Gaddipati, J.; Srimal, R.C. Multiple biological activities of curcumin: A short review. Life Sci. 2006, 78, 2081–2087. [Google Scholar] [CrossRef]
- Castilla-Casadiego, D.A.; Maldonado, M.; Sundaram, P.; Almodovar, J. Green electrospinning of a collagen/hydroxyapatite composite nanofibrous scaffold. MRS Commun. 2016, 6, 402–407. [Google Scholar] [CrossRef]
- Ito, Y.; Hasuda, H.; Kamitakahara, M.; Ohtsuki, C.; Tanihara, M.; Kang, I.-K.; Kwon, O.H. A Composite of Hydroxyapatite with Electrospun Biodegradable Nanofibers as a Tissue Engineering Material. J. Biosci. Bioeng. 2005, 100, 43–49. [Google Scholar] [CrossRef] [PubMed]
- Ming, J.; Zuo, B. A novel electrospun silk fibroin/hydroxyapatite hybrid nanofibers. Mater. Chem. Phys. 2012, 137, 421–427. [Google Scholar] [CrossRef]
- Hou, J.; Wang, Y.; Xue, H.; Dou, Y. Biomimetic Growth of Hydroxyapatite on Electrospun CA/PVP Core–Shell Nanofiber Membranes. Polymers 2018, 10, 1032. [Google Scholar] [CrossRef]
- Antaby, E.; Klinkhammer, K.; Sabantina, L. Electrospinning of Chitosan for Antibacterial Applications—Current Trends, Electrospinning of Chitosan for Antibacterial Applications—Current Trends. Appl. Sci. 2021, 11, 11937. [Google Scholar] [CrossRef]
- Sonseca, A.; Peponi, L.; Sahuquillo, O.; Kenny, J.M.; Giménez, E. Electrospinning of biodegradable polylactide/hydroxyapatite nanofibers: Study on the morphology, crystallinity structure and thermal stability. Polym. Degrad. Stab. 2012, 97, 2052–2059. [Google Scholar] [CrossRef]
- EL-Rafei, A.M. Optimization of the electrospinning parameters of Mn2O3 and Mn3O4 nanofibers”. Ceram. Inter. 2015, 41, 12065–12072. [Google Scholar] [CrossRef]
- Hezma, A.M.; El-Rafei, A.M.; El-Bahy, G.S.; Abdelrazzak, A.B. Electrospun Hydroxyapatite Containing polyvinyl Alcohol Nanofibers Doped with Nanogold for Bone Tissue Engineering. Inter. Ceram. 2017, 66, 96–100. [Google Scholar] [CrossRef]
- Lopresti, F.; Pavia, F.C.; Vitrano, I.; Kersaudy-Kerhoas, M.; Brucato, V.; Carrubba, V.L. Effect of hydroxyapatite concentration and size on morpho-mechanical properties of PLA-based randomly oriented and aligned electrospun nanofibrous mats. J. Mech. Behav. Biomed. Maters. 2020, 101, 103449. [Google Scholar] [CrossRef] [PubMed]
- Chen, B.Z.; Ashfaq, M.; Zhang, X.P.; Zhang, J.N.; Guo, X.D. In vitro and in vivo assessment of polymer microneedles for controlled transdermal drug delivery. J. Drug Target. 2018, 26, 720–729. [Google Scholar] [CrossRef] [PubMed]
- Schiffman, J.D.; Schauer, C.L. Cross-linking chitosan nanofibers. Biomacromolecules 2007, 8, 594–601. [Google Scholar] [CrossRef] [PubMed]
- Muzzarelli, R.A.; Greco, F.; Busilacchi, A.; Sollazzo, V.; Gigante, A. Chitosan, hyaluronan and chondroitin sulfate in tissue engineering for cartilage regeneration: A review. Carbohydr. Polym. 2012, 89, 723–739. [Google Scholar] [CrossRef]
- El-Okaily, M.S.; EL-Rafei, A.M.; Basha, M.; Ghani, N.T.A.; El-Sayed, M.M.H.; Bhaumik, A.; Mostafa, A.A. Efficient drug delivery vehicles of environmentally benign nano-fibers comprising bioactive glass/chitosan/polyvinyl alcohol composites. Inter. J. Biol. Macromol. 2021, 182, 1582–1589. [Google Scholar] [CrossRef] [PubMed]
- Nour Eldeen, G.; Abdel-Rasheed, M.; EL-Rafei, A.M.; Azmy, O.; El-Bassyouni, G.T. Adipose Tissue-Derived Mesenchymal Stem Cells and Chitosan/poly (vinyl alcohol) Nanofibrous Scaffolds for Cartilage Tissue Engineering. Cell Regen. 2020, 9, 7. [Google Scholar] [CrossRef] [PubMed]
- Ismail, M.; Ibrahim, S.; El-Amir, A.; El-Rafei, A.M.; Allam, N.K.; Abdellatif, A. Genistein Loaded Nanofibers Protect Spinal Cord Tissue Following Experimental Injury in Rats. Biomedicines 2018, 6, 96. [Google Scholar] [CrossRef]
- Ibrahim, S.; Sayed, H.M.; EL-Rafei, A.M.; El-Amir, A.; Ismail, M.; Allam, N.K. Improved genistein loading and release on electrospun chitosan nanofiber blends. J. Mol. Liq. 2016, 223, 1056–1061. [Google Scholar] [CrossRef]
- Pankongadisak, P.; Sangklin, S.; Chuysinuan, P.; Suwantong, O.; Supaphol, P. The use of electrospun curcumin-loaded poly(L-lactic acid) fiber mats as wound dressing materials. J. Drug Deliv. Sci. Technol. 2019, 53, 101–121. [Google Scholar] [CrossRef]
- Ranjbar-Mohammadi, M.; Bahrami, S.H. Electrospun curcumin loaded poly(ε-caprolactone)/gum tragacanth nanofibers for biomedical application. Inter. J. Biol. Macromol. 2016, 84, 448–456. [Google Scholar] [CrossRef]
- Mahmud, M.M.; Zaman, S.; Perveen, A.; Jahan, R.A.; Islam, M.F.; Arafat, M.T. Controlled release of curcumin from electrospun fiber mats with antibacterial activity. J. Drug Deliv. Sci. Technol. 2020, 55, 101386. [Google Scholar] [CrossRef]
- Niranjan, R.; Kaushik, M.; Prakash, J.; Venkataprasanna, K.S.; Christy, A.; Pannerselvam, B.; Venkatasubbu, G.D. Enhanced wound healing by PVA/Chitosan/Curcumin patches: In vitro and in vivo study. Coll. Surf. B Biointerfaces 2019, 182, 110339. [Google Scholar]
- Moradkhannejhad, L.; Abdouss, M.; Nikfarjam, N.; Mazinani, S.; Sayar, P. Electrospun curcumin loaded poly(lactic acid) nanofiber mat on the flexible crosslinked PVA/peg membrane film: Characterization and in vitro release kinetic study. Fibers Polym. 2017, 18, 2349–2360. [Google Scholar] [CrossRef]
- Eskitoros-Togay, M.; Bulbul, Y.E.; Dilsiz, N. Combination of nano-hydroxyapatite and curcumin in a biopolymer blend matrix: Characteristics and drug release performance of fibrous composite material systems. Inter. J. Pharm. 2020, 590, 119933. [Google Scholar] [CrossRef] [PubMed]
- Dhurai, B.; Saraswathy, N.; Maheswaran, R.; Sethupathi, P.; Vanitha, P.; Vigneshwaran, S.; Rameshbabu, V. Electrospinning of curcumin-loaded chitosan/poly (lactic acid) nanofilm and evaluation of its medicinal characteristics. Front. Mater. Sci. 2013, 7, 350–361. [Google Scholar] [CrossRef]
- Golchin, A.; Hosseinzadeh, S.; Masumeh Staji, M.; Soleimani, M.; Ardeshirylajimi, A.; Khojasteh, A. Biological behavior of the curcumin incorporated chitosan/poly(vinyl alcohol) nanofibers for biomedical applications. J. Cell Biochem. 2019, 120, 15410–15421. [Google Scholar] [CrossRef]
- Ramdani, R.; Rao, A.M.; Pokharel, M.; Mateti, T.; Likhith, K.; Kumari, M.; Bhatt, S.S.; Nune, M.; Thakur, G. Curcumin-Laden Crosslinked Chitosan–PVA Films: The Synergistic Impact of Genipin and Curcumin on Accelerating Wound Closure. JOM 2023, 75, 5581–5590. [Google Scholar] [CrossRef]
- Thien, D.V.H.; Quyen, T.T.B.; Tri, N.M.; Thoa, T.K.K.; Tham, N.T.N. Electrospun Chitosan/Pva Nanofibers For Drug Deliver. J. Sci. Technol. 2016, 54, 185–192. [Google Scholar]
- Vimala, K.; Mohan, Y.M.; Varaprasad, K.; Reddy, N.; Ravindra, S.; Naidu, N.; Raju. Fabrication of Curcumin Encapsulated Chitosan-PVA Silver Nanocomposite Films for Improved Antimicrobial Activity. J. Biomater. Nanobiotechnol. 2011, 2, 55–64. [Google Scholar] [CrossRef]
- Ali, A.; Abdus Shahid, M.D.; Hossain, M.D.D.; Islam, M.D.N. Antibacterial bi-layered polyvinyl alcohol (PVA)-chitosan blend nanofibrous mat loaded with Azadirachta indica (neem) extract. Intern. J. Biol. Macromol. 2019, 138, 13–20. [Google Scholar] [CrossRef] [PubMed]
- Aycan, D.; Yayla, N.A.; Aydin, Y.A. Chitosan polyvinyl alcohol blend films for ibuprofen encapsulation: Fabrication, characterization and kinetics. Polym. Degrad. Stab. 2020, 181, 109346. [Google Scholar] [CrossRef]
- Al-Mofty, S.E.; Karaly, A.H.; Sarhan, W.A.; Azzazy, H.M.E. Multifunctional Hemostatic PVA/Chitosan Sponges Loaded with Hydroxyapatite and Ciprofloxacin. ACS Omega 2022, 7, 13210–13220. [Google Scholar] [CrossRef] [PubMed]
- Sharifi, S.; Zaheri Khosroshahi, A.; Maleki Dizaj, S.; Rezaei, Y. Preparation, Physicochemical Assessment and the Antimicrobial Action of Hydroxyapatite–Gelatin/Curcumin Nanofibrous Composites as a Dental Biomaterial. Biomimetics 2022, 7, 4. [Google Scholar] [CrossRef] [PubMed]
- Osial, M.; Wilczewski, S.; Godlewska, U.; Skórczewska, K.; Hilus, J.; Szulc, J.; Roszkiewicz, A.; Dąbrowska, A.; Moazzami Goudarzi, Z.; Lewandowski, K.; et al. Incorporation of Nanostructural Hydroxyapatite and Curcumin Extract from Curcuma longa L. Rhizome into Polylactide to Obtain Green Composite. Polymers 2024, 16, 2169. [Google Scholar] [CrossRef] [PubMed]
- Abdal-hay, A.; Sheikh, F.A.; Lim, J.K. Air jet spinning of hydroxyapatite/poly(lactic acid) hybrid nanocomposite membrane mats for bone tissue engineering. Coll. Surf. B Biointerfaces 2013, 102, 635–643. [Google Scholar] [CrossRef]
- Barry, A.L. Procedure for Testing Antimicrobial Agent in Agar Media. In Antibiotica in Laboratory Medicines; Lorianed, V., Ed.; Willims and Wilkins Co.: Baltimore, MA, USA, 1980; pp. 1–23. [Google Scholar]
- Frey, F.M. Meyers, Antibacterial activity of traditional medicinal plants used by Hauden osaunee peoples of New York State. BMC Complement. Altern. Med. 2010, 10, 10–64. [Google Scholar] [CrossRef]
- Mostafa, A.F.; Abd El Aty, A.A.; Hamed, R.E.; Eid, B.M.; Ibrahim, N.A. Enzymatic, kinetic and anti-microbial studies on Aspergillus terreus culture filtrate and Allium cepa seeds extract and their potent applications. Biocat Agric. Biotechnol. 2016, 5, 116–122. [Google Scholar] [CrossRef]
- McFarland, J. The nephelometer: An instrument for estimating the number of bacteria in suspensions used for calculating the opsonic index and for vaccines. J. Am. Med. Assoc. 1907, 49, 1176–1178. [Google Scholar] [CrossRef]
- Zamora, L.L.; Perez-Gracia, M.T. Using digital photography to implement the McFarland method. R. Soc. Interface 2012, 9, 1892–1897. [Google Scholar] [CrossRef] [PubMed]
- El-serwy, W.S.; Mohamed, N.A.; Walaa SEl-Serwy, W.S. Synthesis of New Benzofuran Derivatives and Evaluation of their Antimicrobial Activities. Res. J. Pharm. Biol. Chem. Scis. 2015, 6, 213–224. [Google Scholar]
- Barbalinardo, M.; Gentili, D.; Lazzarotto, F.; Valle, F.; Brucale, M.; Melucci, M.; Favaretto, L.; Zambianchi, M.; Borrachero-Conejo, A.I.; Saracino, E.; et al. Data-Matrix Technology for Multiparameter Monitoring of Cell Cultures. Small Methods 2018, 2, 1700377. [Google Scholar] [CrossRef]
- Barbalinardo, M.; Biagetti, M.; Valle, F.; Cavallini, M.; Falini, G.; Montron, D. Green Biocompatible Method for the Synthesis of Collagen/Chitin Composites to Study Their Composition and Assembly Influence on Fibroblasts Growth. Biomacromolecules 2021, 22, 3357–3365. [Google Scholar] [CrossRef] [PubMed]
- Zheng, F.; Wang, S.; Wen, S.; Shen, M.; Zhu, M.; Shi, X. Characterization and antibacterial activity of amoxicillin-loaded electrospun nano-hydroxyapatite/poly(lactic-co-glycolic acid) composite nanofibers. Biomaterials 2013, 34, 1402–1412. [Google Scholar] [CrossRef] [PubMed]
- Iswarya, S.; Theivasanthi, T.; Gopinath, S.C.B. Sodium alginate/Hydroxyapatite/nanocellulose composites: Synthesis and Potentials for bone tissue engineering. J. Mech. Behav. Biomed. Maters 2023, 148, 106189. [Google Scholar] [CrossRef]
- Lin, C.; Chang, Y.; Cheng, L.; Liu, C.; Chang, S.C.; Hsien, T.; Wang, D.; Hsieh, H. Preparation of graphene-embedded hydroxypropyl cellulose/chitosan/polyethylene oxide nanofiber membranes as wound dressings with enhanced antibacterial properties. Cellulose 2020, 27, 2651–2667. [Google Scholar] [CrossRef]
- Gokcekaya, O.; Ueda, K.; Ogasawara, K.; Kanetaka, H.; Narushima, T. x In vitro evaluation of Ag-containing calcium phosphates: Effectiveness of Ag-incorporated β-tricalcium phosphate. Mater. Sci. Eng. C. 2012, 75, 926–933. [Google Scholar] [CrossRef] [PubMed]
- Brown, L.; Wolf, J.M.; Prados-Rosales, R. Through the wall: Extracellular vesicles in Gram-positive bacteria, mycobacteria and fungi. Nat. Rev. Microbiol. 2015, 13, 620–630. [Google Scholar] [CrossRef] [PubMed]
- Anjani, Q.K.; Utomo, E.; Domínguez-Robles, J.; Detamornrat, U.; Donnelly, R.F.; Larrañeta, E. A new and sensitive HPLC-UV method for rapid and simultaneous quantification of curcumin and D-panthenol: Application to in vitro release studies of wound dressings. Molecules 2022, 27, 1759. [Google Scholar] [CrossRef] [PubMed]
- Bulbul, Y.E.; Okur, M.; Demirtas-Korkmaz, F.; Dilsiz, F. Development of PCL/PEO electrospun fibrous membranes blended with silane-modified Halloysite nanotube as a curcumin release system. Appl. Clay Sci. 2020, 186, 105430. [Google Scholar] [CrossRef]
- Palanisamy, G.; Lee, J.H.; Lee, J. Curcumin-loaded hydroxyapatite nanoparticles for enriched removal of organic pollutants and inhibition of dual-species biofilm formation. Environ. Technol. Innov. 2023, 32, 103364. [Google Scholar] [CrossRef]

| Samples | No. | 1 | 2 | 3 | 4 | 5 | 6 | ||||||||||||||
|---|---|---|---|---|---|---|---|---|---|---|---|---|---|---|---|---|---|---|---|---|---|
| Test Bacteria | Code | A | b | c | a | b | c | a | b | C | a | b | c | a | b | c | A | b | c | ||
| 1 | E. coli | 11 | 13 | 11 | 11 | 12 | 14 | 11 | 12 | 12 | - | - | - | - | - | - | - | - | - | ||
| 2 | S. aureus | 13 | 12 | 14 | 15 | 14 | 13 | 15 | 15 | 13 | 12 | 11 | 13 | - | - | - | - | - | - | ||
| 3 | C. albicans | - | - | - | - | - | - | - | - | - | - | - | - | - | - | - | - | - | - | ||
| Sample | Mathematical Model | Kinetic Constants | Adj-R2 |
|---|---|---|---|
| CS/PVA/Cur nanofiber | First-order: | 0.85 ± 0.28 | 0.46 |
| Higuchi: | 18.99 ± 2.10 | 0.88 | |
| Korsmeyer–Peppas: | 2.2 ± 0.8 1.8 ± 0.2 | 0.91 | |
| Peppas–Salhin: | 2.1 ± 0.4 0.01 ± 0.02 | 0.99 | |
| CS/PVA/HA/Cur nanofiber | First-order: | 0.86 ± 0.14 | 0.68 |
| Higuchi: | 8.43 ± 0.61 | 0.91 | |
| Korsmeyer–Peppas: | 12.25 ± 1.99 0.38 ± 0.05 | 0.94 | |
| Peppas–Salhin: | 11.88 ± 2.49 −0.66 ± 0.26 | 0.94 |
Disclaimer/Publisher’s Note: The statements, opinions and data contained in all publications are solely those of the individual author(s) and contributor(s) and not of MDPI and/or the editor(s). MDPI and/or the editor(s) disclaim responsibility for any injury to people or property resulting from any ideas, methods, instructions or products referred to in the content. |
© 2025 by the authors. Licensee MDPI, Basel, Switzerland. This article is an open access article distributed under the terms and conditions of the Creative Commons Attribution (CC BY) license (https://creativecommons.org/licenses/by/4.0/).
Share and Cite
EL-Rafei, A.M.; Maurizii, G.; Aluigi, A.; Sotgiu, G.; Barbalinardo, M.; Posati, T. Designing and Fabrication of Nano-Hydroxyapatite and Curcumin-Loaded Chitosan/PVA Nanofibrous Mats for Potential Use as Wound Dressing Biomaterials. Nanomaterials 2025, 15, 82. https://doi.org/10.3390/nano15020082
EL-Rafei AM, Maurizii G, Aluigi A, Sotgiu G, Barbalinardo M, Posati T. Designing and Fabrication of Nano-Hydroxyapatite and Curcumin-Loaded Chitosan/PVA Nanofibrous Mats for Potential Use as Wound Dressing Biomaterials. Nanomaterials. 2025; 15(2):82. https://doi.org/10.3390/nano15020082
Chicago/Turabian StyleEL-Rafei, Amira M., Giorgia Maurizii, Annalisa Aluigi, Giovanna Sotgiu, Marianna Barbalinardo, and Tamara Posati. 2025. "Designing and Fabrication of Nano-Hydroxyapatite and Curcumin-Loaded Chitosan/PVA Nanofibrous Mats for Potential Use as Wound Dressing Biomaterials" Nanomaterials 15, no. 2: 82. https://doi.org/10.3390/nano15020082
APA StyleEL-Rafei, A. M., Maurizii, G., Aluigi, A., Sotgiu, G., Barbalinardo, M., & Posati, T. (2025). Designing and Fabrication of Nano-Hydroxyapatite and Curcumin-Loaded Chitosan/PVA Nanofibrous Mats for Potential Use as Wound Dressing Biomaterials. Nanomaterials, 15(2), 82. https://doi.org/10.3390/nano15020082

